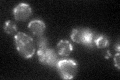
YPR020W
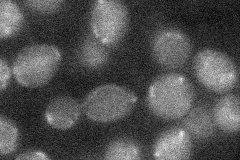
YPR020W

View description
Subunit g of the mitochondrial F1F0 ATP synthase; reversibly phosphorylated on two residues; unphosphorylated form is required for dimerization of the ATP synthase complex
Localization:
Intensity:
Fold change:
Significance:
-
C’ GFP library in SD
mitochondria31.64 -
N' NOP1pr-GFP in SD

below threshold14.1627 -
N' TEF2pr-mCherry in SD

mitochondria70.5717 -
N' NATIVEpr-GFP in SD

below threshold17.7905 -
N' TEF2pr-VC and Cyto-VN in SD
below threshold20.6293 -
C’ GFP library in SD+DTT

mitochondria24.460.77No -
C’ GFP library in SD+H2O2

mitochondria22.050.69Yes -
C’ GFP library in Starvation Media

mitochondria45.771.44Yes -
C’ GFP library on the background of Pup2-DaMP

mitochondria -
C’ GFP library on the background of CCT mutant

mitochondria23.55230.744366No
